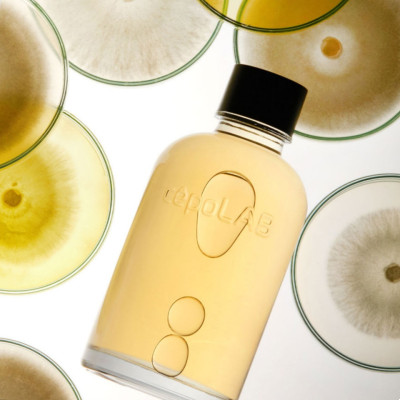

您的購物車沒有添加商品!
Dr Melaxin 逆齡再生水油平衡保濕噴霧,含牡蠣提取的珍貴成分,有效抑制皮膚老化毒素,重生膠原蛋白。韓國配方,提供強效保濕和激活膠原自生能..
HK$138
這款來自韓國專業醫美品牌 Dr.Melaxin 的TX去角質美白爽膚水,性質溫和,適合每日使用。能輕柔去除多餘角質,幫助護膚..
HK$99
Cepolab 90%臭水 (濕疹/敏感救星)155ML
具有強大生命力的生理活性物質,奈米顆粒滲透至皮膚深處,提供黃金能量,喚醒沉睡的皮膚細胞,對抗老化跡象,提升皮膚質素,促進皮膚的自然健康‼..
HK$299
Lamer 奇跡水蘊藏四大活膚功效再生修護+保濕滋養+舒緩調理+勻亮膚色,如同肌膚的能量電池,為肌膚活&l..
HK$190 HK$186
夠白!夠水潤!橙➕藍等於咩 唔洗諗 即刻答到你 係前所未有嘅激白體驗 啡棕黑黃紅 色素深層打散 唔怕斑斑特變❌ 唔怕痘印長留❌ 更加唔怕化身「黃大媽」
美容界KOL @小..
HK$478
此產品體積較大&重身
建議 使用速遞勿郵寄!
♬♩♪♫♭♪♬♩♪♫♬♩♪♬♩♪♫♬♩♪♫
陳珮騏愛用推薦 電購激賣上萬組
1滴滲入豐沛精華
保濕精華安瓶原液
專為亞洲內油外..
HK$99
Nature tree精華液終於有面膜紙配合一齊使用啦!
大家以後唔需要周圍搵啦…☺☺
蠶絲透簿如透明
鎖水功能超高
滲透力強不容易破爛
..
HK$110
Dr.Melaxin Exosome 積雪草抗敏痘印修護爽膚水 300ml
韓國專業醫美品牌 Dr.Melaxin | 逆齢專家
..
HK$118
SO NATURAL CENTELLA SKIN CALMING TONER
積雪草皮膚鎮靜爽膚水
很多研究都已經顯示積雪草萃取
可以增生膠原蛋白並促進皮..
HK$180
KIEHL'S Greatest Hits set 8件正裝套裝 成套總值$25xx(原價)
現超值內含8 件明星商品:
▪️冰河保濕潔面乳 Ultra Facial Cleanser..
HK$2,548 HK$880